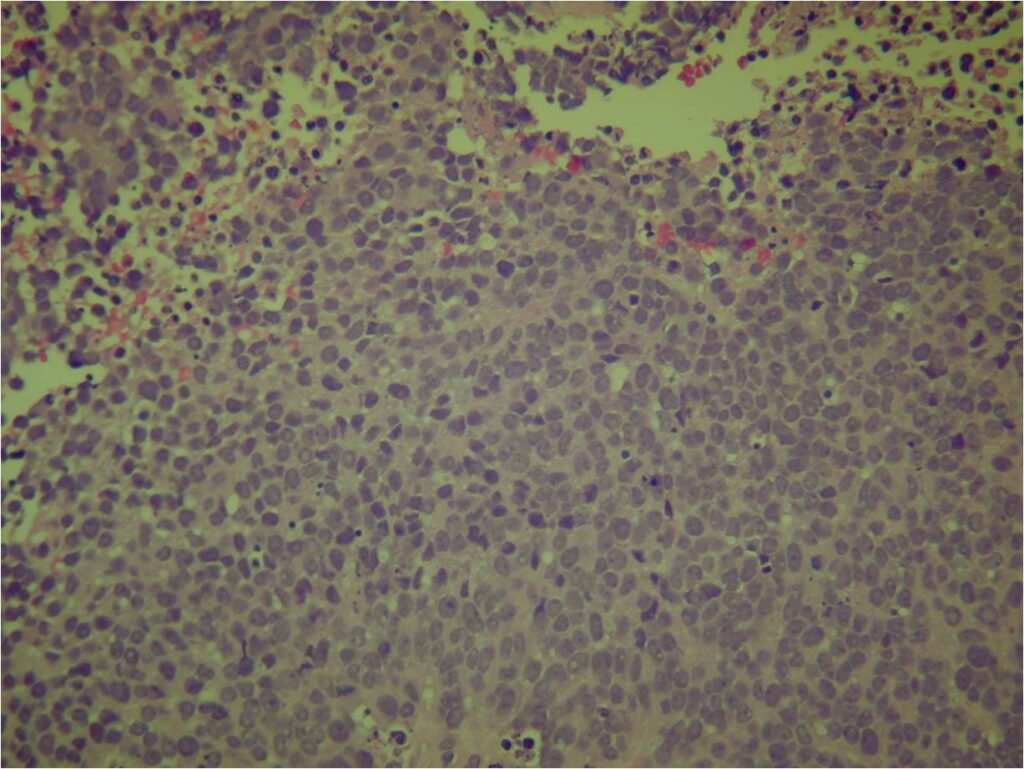

General Information
- Ewing sarcoma is a small round blue cell sarcoma
- It is a primary osseous neoplasm (cancer/sarcoma) composed of uniform, monotonous, small round blue cells without any matrix production
- Fourth most common primary malignancy of bone
- Approximately 5% of all biopsied tumors
- Least differentiated of neuroectodermal neoplasms
- Consistent presence of chromosomal abnormality
- Occurs primarily in long bones
- Most Ewing sarcoma cases (85%) are associated with a characteristic chromosomal translocation t(11;22)(q24;q12) that results in EWS/FLI-1 chimeric protein
Clinical Presentation
Signs/Symptoms:
- Mass & localized pain.
- Increased sedimentation rate, fever, anemia, malaise may occur and are usually indicative of metastatic disease
- 10% of patients present with multiple bony lesions
- May have elevated LDH
Prevalence:
- Slight male predominance (1.5:1)
- Uncommon in African Americans
Age:
- 80% cases occur in first two decades, median age is 13
- 10-25 years of age most common
Sites:
- Most commonly arises from diaphysis but can also arise from metadiaphysis and metaphysis;
- Very rare epiphyseal involvement
- Long Bones – Most common
- Femur: Single most common site
- Humerus
- Flat Bones
- Pelvis
- Ribs
Radiographic Presentation
- Permeative or moth eaten bone destruction
- Ill defined and malignant appearing
- Bony changes are often subtle
- Soft Tissue Mass in 90% of of cases
- Periosteal Reaction in 50% of cases
- Due to irritation, edema, tumor permeation
- Onion Skin (colic pattern of irritation)
- Hair on End (rapid continuous lifting of periosteum)
- Reactive Bone Sclerosis is rare but occurs in 10% of cases
- No cartilage or bone production by tumor
- Pathologic fracture in 10-15%
- Ewing sarcoma rarely presents as a geographic, benign appearing tumor similar to a cyst or eosinophilic granuloma
- There are rare cases of periosteal ewing sarcoma with no medullary involvement














Gross Pathology
- Intraosseous component
- Firm, grey-white, moist, and glistening
- Extraosseous component
- Softer and more friable
- Hemorrhagic and cystic degeneration may be present in either location
- Diffuse involvement of the medullary cavity is often obvious





Microscopic Pathology
- Ewing sarcoma is composed of undifferentiated, small round, polygonal mesenchymal cells rich in glycogen
- Sheets of uniform cells with scanty pale cytoplasm and indistinct cell boarders
- No Matrix
- Nuclei are round/oval with finely dispersed chromatin
- Virtually no cytoplasm
- Areas of necrosis
- Variable number of mitoses
- Cells are similar in appearance
- Geographic necrosis with perivascular sparing
- Metaplastic bone or cartilage formation
- Chromosomal Translocation t(11;22)(q24;q12)
- PAS (glycogen positive); Reticulin stain poor
- Immunostains: Vimentin (+), CD99 (+); Leukocyte Antigen Negative
- Overexpress MIC2 detected by CD99
- Does not express neuroectodermal antigens

Small Round Blue Cells No Matrix Large Nuclei No Cytoplasm
Differential Diagnosis
- Small Cell Osteosarcoma
- Mesenchymal Chondrosarcoma
- Lymphoma
- Matastatic Neuroblastoma
- Primitive Neuroectodermal Tumor (PNET) of Bone
- In same family as Ewing sarcoma but worse prognosis
- Treated in same manner
- Pseudorosette formation
- Electron microscope: Cells with cytoplasmic processes
- Express neuroectodermal markers: Neuron Specific Enolase, Synaptophysin, Leu-7
Biological Behavior
- Ewing sarcoma is one of the most aggressive tumors
- High propensity for Local recurrences
- Distant metastases (predominantly in lungs and other bones)
- Noted for its lack of immunologic staining
Treatment
- Multiagent chemotherapy
- Most protocols administer preoperative chemotherapy then surgery is performed. Surgery is followed by several courses of postoperative chemotherapy.
- Ewing sarcoma responds well to chemotherapy. Often there is a dramatic reduction in size of the tumor.
- Most common chemotherapy agents utilized include as of 2008: Vincristine, Adriamycin, Cyclophosphamide, Actinomycin-D, Ifosfamide, Etoposide
- Surgical resection
- Limb sparing surgery whenever feasible unless there will be a large leg length discrepancy that can not be accomodated for with surgery
- Rarely ever an amputation since Ewing sarcoma are sensitive to radiation
If surgical resection is not feasible, radiation may be utilized for local control (instead of an amputation) since Ewing sarcoma is highly sensitive to radiation, at least as per the author’s opinion. There may be some tumors that are selectively treated with radiation instead of surgery however most patients as of 2008 are treated with limb sparing surgery whenever feasible. Sometimes radiation is used in conjunction with surgery if a wide margin was not obtained at the time of surgery. The decision to administer radiation depends on size of tumor, site of tumor, response of tumor to preoperative chemotherapy and risks vs benefits of radiation.










Prognosis
- Patients with localized, resectable disease
- 5 year survival 54%-74% as of 2008
- Patients with disseminated disease at diagnosis
- 5 year survival 30%
- Surgical removal of resectable lung metastases improves survival
- Patients 10 years or younger have better response to treatment and better survival
- Pelvic Ewing sarcoma have a worse prognosis than other areas
- Lesions grossly confined to bone have a better prognosis than those with a soft tissue component
- Response to preoperative chemotherapy: Greater than 90% tumor necrosis (Good response) correlates with a better prognosis
- Tumors greater than 8cm in maximum dimension and those with greater than a volume of 100cc have been associated with a worse prognosis
Other Important Information
- Patients under 5 years of age should be carefully evaluated to exclude metastatic neuroblastoma
- Large cell variant of Ewing sarcoma exists, which may be confused with large cell lymphoma